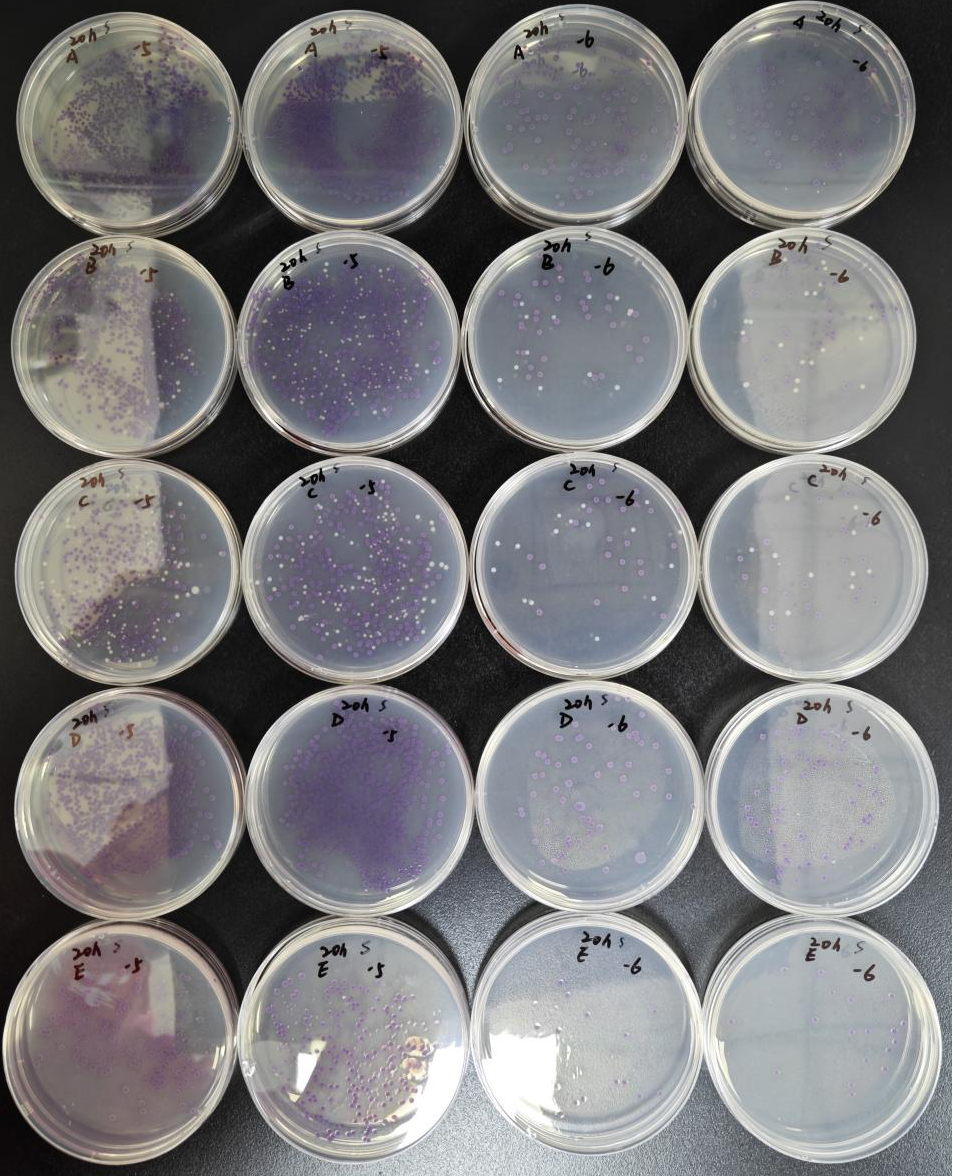
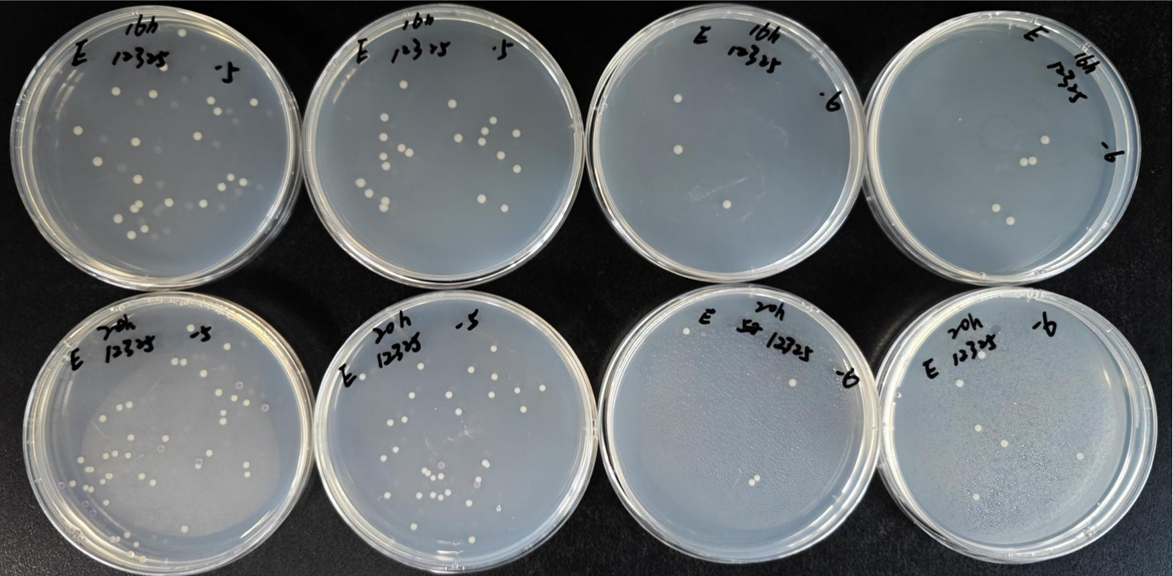

? ??
GB4789.4-202*《食品安全國家標(biāo)準(zhǔn) 食品微生物檢驗(yàn) 沙門氏菌檢驗(yàn)》征求意見稿和2023版《國家食品污染和有害因素風(fēng)險監(jiān)測工作手冊》[1]����,最大的變動之一是將SC更換為RVS。 RVS作為一個新的培養(yǎng)基被列入了食品安全國家標(biāo)準(zhǔn)的檢測行列�����,但GB4789.28-2013《食品安全國家標(biāo)準(zhǔn) 食品微生物學(xué)檢驗(yàn) 培養(yǎng)基與試劑的質(zhì)量要求》[2]及其征求意見稿中均未列入該培養(yǎng)基�����,如何對其進(jìn)行質(zhì)控?各廠家的RVS增菌效果是否相同��?對此��,我們做了相關(guān)驗(yàn)證��。
? ?
?
RVS肉湯的原理
培養(yǎng)基中大豆胨提供菌體細(xì)胞生長所需的碳源���、氮源等����;氯鹽可以提高培養(yǎng)基體系的滲透壓���,磷酸鹽作為緩沖體系維持培養(yǎng)基酸性環(huán)境(pH 5.2±0.2)���,孔雀綠可以抑制非沙門氏菌屬細(xì)菌的生長。該培養(yǎng)基的選擇性表現(xiàn)在高滲透壓���、低pH值以及孔雀綠的抑菌效果[3]��。


圖:3:RVS肉湯
?
RVS肉湯的質(zhì)控方法及比對結(jié)果
對比國內(nèi)外5個廠家(A?B C D E��,其中A為陸橋)的RVS增菌液���,按照GB 4789.28-2013 《食品安全國家標(biāo)準(zhǔn) 食品微生物學(xué)檢驗(yàn) 培養(yǎng)基和試劑的質(zhì)量要求》附錄D中SC增菌液的質(zhì)控方法���,對RVS增菌液進(jìn)行驗(yàn)證���,結(jié)果無顯著性差異����。
?
RVS肉湯的進(jìn)一步驗(yàn)證
各廠家RVS增菌液質(zhì)控結(jié)果無顯著性差異���,是否在實(shí)際檢驗(yàn)中增菌效果就一致呢��?樣品中通常含有大量的雜菌����,我們模擬實(shí)際檢測將非目標(biāo)菌含量提高���,參考質(zhì)控方法���,選用不同血清型的沙門氏菌與大腸埃希氏菌ATCC25922混合�。選擇低于標(biāo)準(zhǔn)要求的16h和標(biāo)準(zhǔn)范圍內(nèi)的20h����,觀察增菌速度和增菌效果,開展了進(jìn)一步的驗(yàn)證試驗(yàn)����。
?
實(shí)驗(yàn)方法:
不同血清型的沙門氏菌(接種量小于50CFU)與大腸埃希氏菌ATCC25922?(接種量為106CFU)混合后接種RVS增菌液,于42℃±1℃培養(yǎng)���,分別于16h和20h取增菌液��,稀釋到適宜濃度后轉(zhuǎn)接到沙門氏菌顯色(SA)(陸橋二代)平板上進(jìn)行計(jì)數(shù)����,觀察目標(biāo)菌和非目標(biāo)菌的生長情況��。在SA培養(yǎng)基上����,目標(biāo)菌沙門氏菌呈紫紅色,大腸埃希氏菌為無色���。
?
菌株信息:
 ?
?
?
結(jié)果:?
對于ATCC14028,CMCC(B)50976和CICC25045�,廠家A和廠家D對目標(biāo)菌的增菌效果最優(yōu),廠家A�����、D��、E的抑制性最優(yōu)�。(見附錄1?以ATCC14028為例)
對于ATCC29934,ATCC12325,CMCC50115和ATCC13076�����,廠家A對目標(biāo)菌增菌效果最優(yōu)���,廠家A和D的抑制性最優(yōu)�����。(見附錄2?以ATCC12325為例)
?
結(jié)論:
由多個實(shí)驗(yàn)結(jié)果可以得出���,綜合7株沙門氏菌的增菌效果和大腸埃希氏菌的抑制性,廠家A(陸橋)最佳����。廠家A(陸橋)可較好的抑制非目標(biāo)菌--大腸埃希氏菌的生長���,有效避免了其對沙門氏菌產(chǎn)生的競爭性抑制,同時能夠保證目標(biāo)菌沙門氏菌良好的促生長能力��。
? 廠家B和廠家C的表現(xiàn)基本一致����,主要是抑制性較差,按照該實(shí)驗(yàn)方法����,7次混菌實(shí)驗(yàn)都有大量非目標(biāo)菌的生長,這會增加日常檢測的工作量���,且對于腸道沙門氏菌雙相亞利桑那亞種存在漏檢的風(fēng)險��。
? 廠家D的表現(xiàn)與廠家A相似���,但是對于腸沙門氏菌腸亞種鼠傷寒血清型CMCC(B)50115和腸道沙門氏菌亞種ATCC13076生長較差,對于腸道沙門氏菌雙相亞利桑那亞種ATCC29934和ATCC12325的增菌速度慢且數(shù)量少�,也存在漏檢風(fēng)險。
廠家E的主要問題是對大多數(shù)目標(biāo)菌的增菌能力較弱�����,有時會低其他廠家1個數(shù)量級。
?
附錄1:
?
 ?
?

圖4:培養(yǎng)16h���,5個廠家接種混菌ATCC14028+ATCC25922的生長情況�,涂布SA
從上到下依次為A?B C D E
圖5:培養(yǎng)20h�����,5個廠家接種混菌ATCC14028+ATCC25922的生長情況���,涂布SA
從上到下依次為A?B C D E
?
?
附錄2:

?
 ?
?
圖6:廠家A(陸橋)在16h(上)和20h(下)的混菌ATCC12325+ATCC25922生長情況

圖7:廠家B在16h(上)和20h(下)的混菌ATCC12325+ATCC25922生長情況

圖8:廠家C在16h(上)和20h(下)的混菌ATCC12325+ATCC25922生長情況

圖9:廠家D在16h(上)和20h(下)的混菌ATCC12325+ATCC25922生長情況
?
圖10:廠家E在16h(上)和20h(下)的混菌ATCC12325+ATCC25922生長情況
????
?
?
附錄:3

?

參考文獻(xiàn)
[1]2023年國家食品污染和有害因素風(fēng)險監(jiān)測工作手冊[S]
[2]?GB4789.28-2013�����,《食品安全國家標(biāo)準(zhǔn) 培養(yǎng)基與試劑的檢查要求》[S]
[3]李瑾,劉振,何艷玲.微生物干粉培養(yǎng)基質(zhì)控圖解手冊[M].北京科學(xué)技術(shù)出版社,2007.